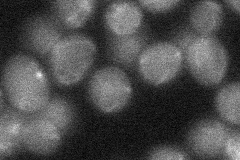
YOR049C

View description
Suppressor of sphingoid long chain base (LCB) sensitivity of an LCB-lyase mutation; putative integral membrane transporter or flippase that may transport LCBs from the cytoplasmic side toward the extracytoplasmic side of the membrane
Localization:
Intensity:
Fold change:
Significance:
-
C’ GFP library in SD

cytosol21.19 -
N' NOP1pr-GFP in SD

vacuole,bud neck44.7661 -
N' TEF2pr-mCherry in SD

vacuole47.1763 -
N' NATIVEpr-GFP in SD

below threshold19.5042 -
N' TEF2pr-VC and Cyto-VN in SD
below threshold22.9761 -
C’ GFP library in SD+DTT

cytosol22.191.04No -
C’ GFP library in SD+H2O2

cytosol21.551.01No -
C’ GFP library in Starvation Media

cytosol28.131.32No -
C’ GFP library on the background of Pup2-DaMP

cytosol -
C’ GFP library on the background of CCT mutant

cytosol23.79261.12226No
